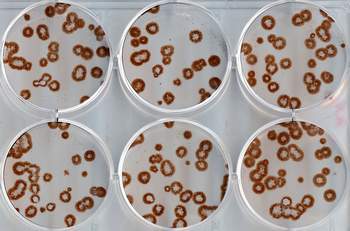
877nuoi-cay-virus.jpg

Sự bí hiểm và nguy hiểm của virut cúm A/H1N1/2009
Virut
cúm A/H1N1/2009 thông thường nhất là gây nên một bệnh cúm lành tính,
với những dấu hiệu nhẹ, sốt vừa phải, ho. Không ít ca mắc bệnh đã tự
khỏi mà người ta không nhận biết được. Tuy nhiên, nếu cúm mùa (grippe
saisonnière) gây ra tỷ lệ tử vong 1/1.000 và nhóm tuổi bệnh nặng chủ
yếu là người lớn tuổi và những người có bệnh lý mạn tính thì hiện nay,
cúm A/H1N1/2009 gây tỷ lệ tử vong là 2 – 3/1.000 người hoặc nhiều hơn.
Mặc dù chưa đầy đủ thông tin để kết luận, nhưng cúm A/H1N1/2009 dường
như hơi dè chừng với những người già (có ý kiến cho rằng nguyên nhân là
người già đã được miễn dịch trước đây bởi các bệnh cúm đã bị mắc phải).
Ngược lại, lứa tuổi 20-30 dường như nhạy cảm hơn. Một điểm khác biệt
nữa là thực tế lâm sàng cho thấy các tổn thương phổi thường có trong
cúm mùa chủ yếu có nguyên nhân nhiễm khuẩn vì lý do bội nhiễm nhưng ở
những thể nặng của cúm A/H1N1/2009, các nhà khoa học nhận thấy sự liên
hệ trực tiếp các tổn thương này với virut cúm A/H1N1/2009.
Còn
nhớ trận cúm Tây Ban Nha năm 1918, đại dịch cũng được xác định là do
cúm A/H1N1 đã làm cho hàng triệu người chết nhưng chủ yếu là bởi vì hồi
đó chưa có các thuốc kháng sinh. Các nhà khoa học cho rằng, virut cúm
khi đó gây kích thích phế quản, tạo điều kiện thuận lợi cho một số bệnh
phổi tiềm tàng phát triển làm tổn thương phổi và gây tử vong. Trong vài
trường hợp đặc biệt, virut cũng có thể gây nên một bệnh phổi đột mạnh
do virut, đưa đến một tình trạng suy hô hấp cấp tính chết người. Nhưng
điều đó khác với sự tàn phá của virut cúm A/H1N/2009 hiện nay. Chính vì
thế, cơ chế tàn phá thực sự của virut cúm A/H1N1/2009 hiện nay là gì
thì chưa có lời giải nào thuyết phục.
Nuôi cấy virut.
Mặt
khác, kết quả xét nghiệm nhiều ca ở Mỹ cho thấy, một số lượng rất lớn
người được cho là khoẻ mạnh, không có biểu hiện cúm, thậm chí không
dương tính với xét nghiệm phát hiện virut cúm A/H1N1/2009 vẫn xuất hiện
kháng thể chống virut cúm A/H1N1/2009. Các nhà nghiên cứu đã tính toán
rằng, khi 500 trường hợp dương tính đã được ghi nhận, thì trên thực tế
hẳn phải có từ 20.000 – 40.000 người bệnh.
Những điều đó càng làm cho virut cúm A/H1N1/2009 “bí hiểm” và nguy hiểm.
Virut cúm kháng tamiflu – chuyện có thật
Tháng
7, Công ty dược phẩm Roche, Thụy Sĩ lần đầu tiên xác nhận trường hợp
kháng thuốc tamiflu. Mặc dù các bệnh nhân này đã được điều trị khỏi
bằng thuốc chống virut cúm có tên Relenza của Công ty dược phẩm
GlaxoSmithKline (GSK). Tuy vậy, phát ngôn viên của Roche (Thụy Sĩ)
khẳng định hiện tượng kháng thuốc này là rất “bình thường”: “Đây là một
điều hết sức bình thường. Khoảng 0,4% nguời lớn có hiện tượng kháng
thuốc khi dùng tamiflu”. Và điều này không có ý nghĩa rằng tamiflu sẽ
“mất” khả năng chống cúm A/H1N1/20009.

(Ảnh minh họa: cpv.org.vn)
Virut
mà đặc biệt là virut cúm luôn luôn thay đổi hình dạng để có khả năng
thích ứng với các tác động bên ngoài trong đó có thuốc. Nguyên nhân của
hiện tượng này là vì bản thân nó không có cơ chế chỉnh sửa các sai sót
trong quá trình sao chép vì thế mà cấu trúc gen ở những virut mới sinh
ra có nhiều biến đổi so với nguyên bản ban đầu. Điều này làm xuất hiện
các phân týp virut mới với những kháng nguyên mới. Đến nay, người ta
liệt kê virut cúm A đã thay đổi đến 15 kháng nguyên hemagglutinine
(đánh số H1 – H15) và 9 kháng nguyên neuraminidase (đánh số từ N1 đến
N9). Hơn thế nữa, virut cúm còn có thể trao đổi, trộn lẫn chất liệu gen
để chuyển từ loài này sang loài khác và sản sinh ra virut lai – chính
là một phân týp virut mới. Do đó có thể vào lúc này, virut là “đích tác
dụng” của một số thuốc kháng virut, nhưng vào lúc khác, nó lại thay đổi
và không còn là “đích tác dụng” của các thuốc đó nữa.
Các phương pháp phòng ngừa
Khi
dịch cúm A/H5N1 xuất hiện, Cơ quan Quản lý Thuốc và Thực phẩm Hoa Kỳ
(FDA) đã cấp phép cho dùng tamiflu và relenza để điều trị. Đầu năm
nay, sau khi dịch cúm A/H1N1/2009 xuất hiện ở Mexico, hai dược phẩm này
vẫn được phép sử dụng để điều trị. Hiện relenza được phép dùng để điều
trị cúm thông thường, không có biến chứng, cho bệnh nhân (người lớn và
trẻ em trên 7 tuổi) bị cúm. Những bệnh nhân có triệu chứng cúm không
quá 2 ngày có thể dùng relenza phòng ngừa cúm cho bệnh nhân người lớn
và trẻ em từ 5 tuổi trở lên. Còn tamiflu được coi là chủ lực trong điều
trị cúm A/H1N1/2009 nhưng chỉ dùng ngay trong vòng 72 giờ kể từ khi có
triệu chứng đầu tiên. Ngoài hai dược phẩm này, còn có amantadine và
rimantadine.
|
Các |
Trước mắt, theo
Tổ chức Y tế Thế giới (WHO), châu Mỹ là lục địa bị dịch nặng nhất sẽ có
đủ thuốc tamiflu để đối phó với dịch bệnh trong thời gian tới và lượng
thuốc sẽ được bổ sung thêm 420.000 liều tamiflu do Chính phủ Mỹ tặng
cho các nước châu Mỹ Latinh và vùng Caribê. Hãng dược phẩm Roche đã hứa
cung cấp 5,6 triệu liều thuốc để WHO phân phát cho các quốc gia nghèo
nhất tại lục địa này. Tuy nhiên, để đảm bảo cho một tương lai lâu dài,
vấn đề cần đặt ra là chuyển giao công nghệ cho các nước phía nghèo để
các nước này có thể tự sản xuất thuốc kháng virut và vaccin.
WHO
cho biết, hiện virut này vẫn nhạy cảm với tamiflu, relenza, nhưng đã
kháng với amantadine. Vì thế, việc phát hiện sớm, điều trị sớm là vô
cùng quan trọng, tránh hiện tuợng kháng thuốc. Hơn nữa, việc sử dụng
đúng tamiflu và điều quyết định trong các hoạt động điều trị cúm A nói
chung và cúm A/H1N1/2009 nói riêng. WHO khẳng định rằng sử dụng tamiflu
nhất thiết phải theo chỉ dẫn của bác sĩ và phải đúng thời điểm. Việc
dùng tamiflu quá trễ hoặc quá sớm (với mong muốn phòng ngừa) hay tự ý
dùng bừa bãi sẽ dẫn đến hiểm họa loài người sẽ bất lực trước sự tàn phá
của con virut bí hiểm này.
Trong khi đó, mặc dù liên tục có các
thông báo khả quan về kết quả nghiên cứu, thử nghiệm, thậm chí là sản
xuất các vaccin ngừa cúm được nhiều quốc gia, nhiều hãng dược phẩm trên
thế giới đưa ra, nhưng cho đến nay, một vaccin thực sự hiệu quả với cúm
A/H1N1/2009 vẫn chưa được Tổ chức Y tế Thế giới khẳng định. Sở dĩ như
vậy là vì, mỗi viện bào chế sản xuất vaccin theo những cơ chế và quy
trình khác nhau hơn nữa chưa có được các kết quả thử nghiệm trên lâm
sàng.
ThS. Phạm Nam – www.suckhoedoisong.vn

